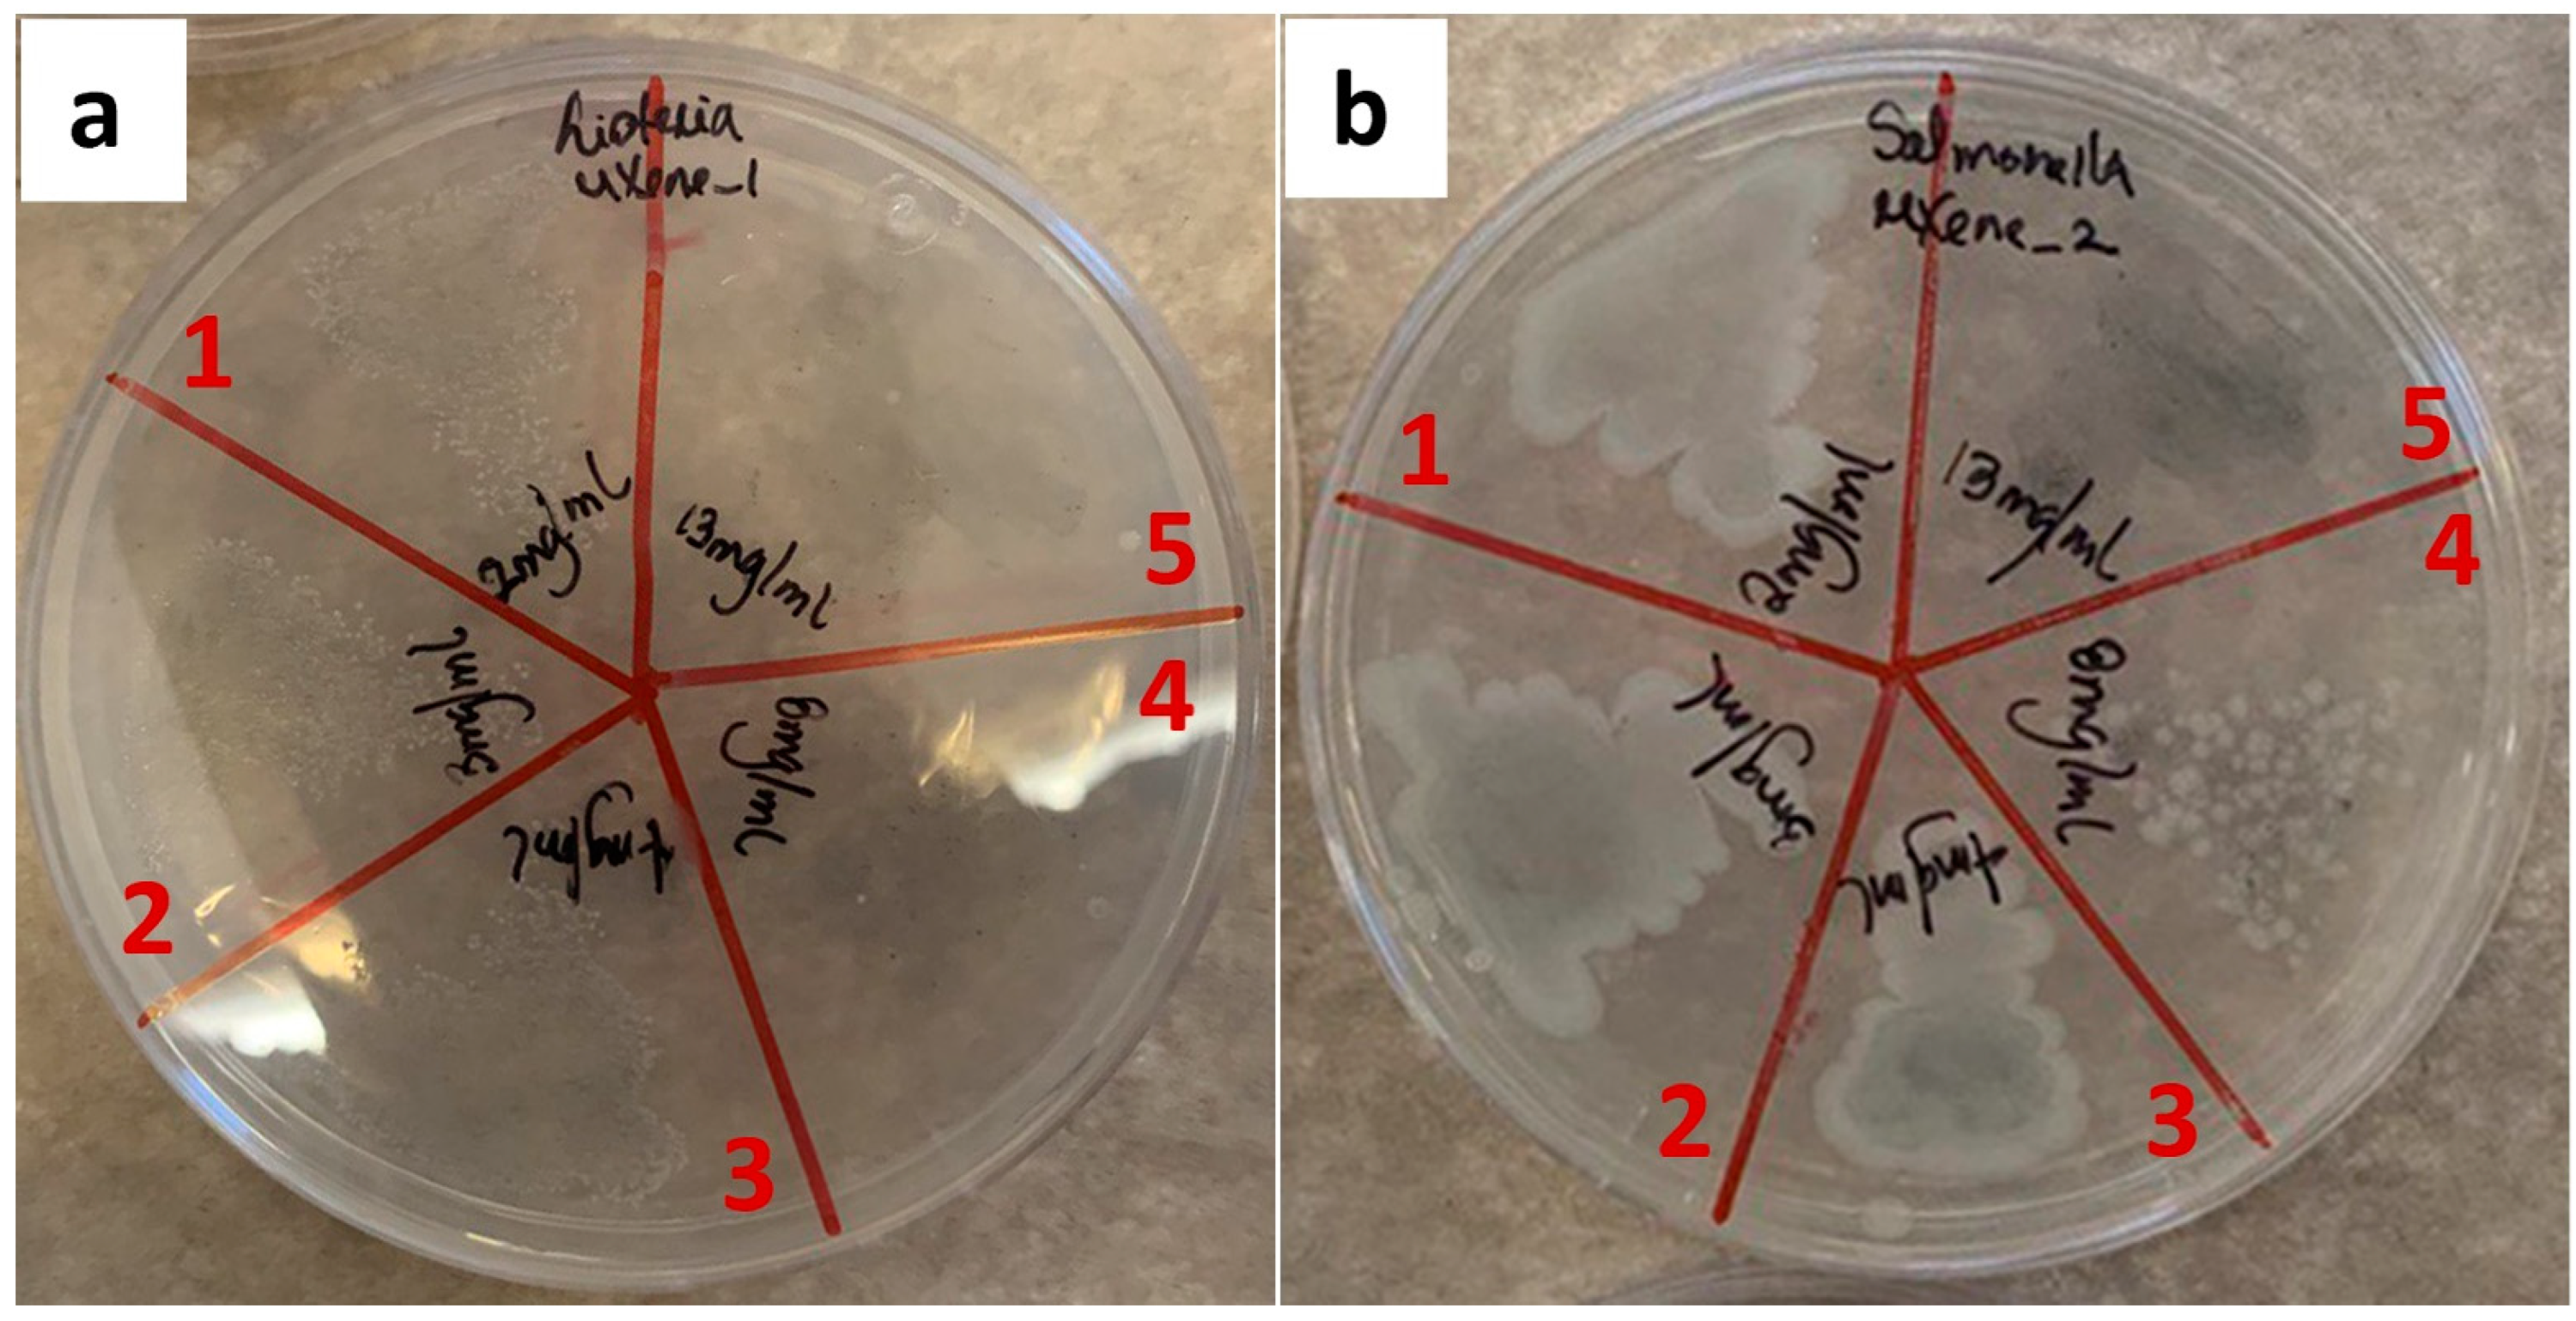
Membranes 12 01146 g002 Membranes 12 01146 g002

Antibacterial Capability of MXene (Ti3C2Tx) to Produce PLA Active Contact Surfaces for Food Packaging Applications
Abstract
1. Introduction
2. Materials and Methods
2.1. Materials
2.2. Methodology for MXene (Ti3C2Tx) Synthesis
2.3. Methodology for the Preparation of PLA/MXene Composite Films
2.4. Material Characterization
2.4.1. MXene Particles
2.4.2. PLA/MXene Composites
3. Results and Discussion
3.1. MXene Filler
3.1.1. Antibacterial Activity
3.2. PLA/MXene Composites
3.2.1. Thermal Characterization
3.2.2. Mechanical Characterization
3.2.3. Cytotoxicity
3.2.4. Antibacterial Activity
4. Conclusions
Author Contributions
Funding
Institutional Review Board Statement
Informed Consent Statement
Data Availability Statement
Conflicts of Interest
References
- Smith, J.P.; Ramaswamy, H.S.; Simpson, B.K. Developments in food packaging technology. Part II. Storage aspects. Trends Trends Food Sci. Technol. 1990, 1, 111. [Google Scholar] [CrossRef]
- Herrador, Z.; Gherasim, A.; López-Vélez, R.; Benito, A. Listeriosis in Spain based on hospitalisation records, 1997 to 2015: Need for greater awareness. Eurosurveillance 2019, 24, 1800271. [Google Scholar] [CrossRef] [PubMed]
- Cortés, V.; Sevilla-Navarro, S.; García, C.; Marín, C.; Catala-Gregori, P. Monitoring antimicrobial resistance trends in Salmonella spp. from poultry in Eastern Spain. Poult Sci. 2022, 101, 101832. [Google Scholar] [CrossRef] [PubMed]
- Domínguez, C.; Gómez, I.; Zumalacarregui, J. Prevalence of Salmonella and Campylobacter in retail chicken meat in Spain. Int. J. Food Microbiol. 2002, 72, 165–168. [Google Scholar] [CrossRef]
- Schlech, W.F. Listeria Gastroenteritis—Old syndrome, New Pathogen. N. Engl. J. Med. 1997, 336, 130–132. [Google Scholar] [CrossRef]
- Silk, B.J.; Date, K.A.; Jackson, K.A.; Pouillot, R.; Holt, K.G.; Graves, L.M.; Ong, K.L.; Hurd, S.; Meyer, R.; Marcus, R. Invasive Listeriosis in the Foodborne Diseases Active Surveillance Network (FoodNet), 2004—2009: Further Targeted Prevention Needed for Higher-Risk Groups. Clin. Infect Dis. 2012, 54, S396–S404. [Google Scholar] [CrossRef]
- Martínez-Avilés, M.; Garrido-Estepa, M.; Álvarez, J.; Torre, A. Salmonella Surveillance Systems in Swine and Humans in Spain: A Review. Vet. Sci. 2019, 6, 20. [Google Scholar] [CrossRef]
- Smith, J.P.; Ramaswamy, H.S.; Simpson, B.K. Developments in food packaging technology. Part I: Processing/cooking considerations. Trends Food Sci. Technol. 1990, 1, 107. [Google Scholar] [CrossRef]
- Lim, G.P.; Soon, C.F.; Ma, N.L.; Morsin, M.; Nayan, N.; Ahmad, M.K.; Tee, K.S. Cytotoxicity of MXene-based nanomaterials for biomedical applications: A mini review. Environ. Res. 2021, 201, 111592. [Google Scholar] [CrossRef]
- Sivasankarapillai, V.S.; Somakumar, A.K.; Joseph, J.; Nikazar, S.; Rahdar, A.; Kyzas, G.Z. Cancer theranostic applications of MXene nanomaterials: Recent updates. Nano-Struct Nano-Objects 2020, 22, 100457. [Google Scholar] [CrossRef]
- Chen, K.; Chen, Y.; Deng, Q.; Jeong, S.; Jang, T.; Du, S.; Kim, H.; Huang, Q.; Han, C. Strong and biocompatible poly(lactic acid) membrane enhanced by Ti3C2Tz (MXene) nanosheets for Guided bone regeneration. Mater. Lett. 2018, 229, 114–117. [Google Scholar] [CrossRef]
- Rasool, K.; Helal, M.; Ali, A.; Ren, A.E.; Gogotsi, Y.; Mahmoud, K.A. Antibacterial Activity of Ti3C2Tx MXene. ACS Nano 2016, 10, 3674–3684. [Google Scholar] [CrossRef]
- Shamsabadi, A.A.; Mohammad, S.; Anasori, B.; Soroush, M. Antimicrobial Mode-of-Action of Colloidal Ti3C2Tx MXene Nanosheets. ACS Sustain. Chem. Eng. 2018, 6, 16586–16596. [Google Scholar] [CrossRef]
- Liu, D.; Gao, Y.; Song, Y.; Zhu, H.; Zhang, L.; Xie, Y.; Shi, H.; Shi, Z.; Yang, Q.; Xiong, C. Highly Sensitive Multifunctional Electronic Skin Based on Nanocellulose/MXene Composite Films with Good Electromagnetic Shielding Biocompatible Antibacterial Properties. Biomacromolecules 2022, 23, 182–195. [Google Scholar] [CrossRef]
- Arman Alim, A.A.; Mohammad Shirajuddin, S.S.; Anuar, F.H. A Review of Nonbiodegradable and Biodegradable Composites for Food Packaging Application. J. Chem. 2022, 2022, 7670819. [Google Scholar] [CrossRef]
- Ahmed, J.; Varshney, S.K. Polylactides-Chemistry, Properties and Green Packaging Technology: A Review. Int. J. Food Prop. 2011, 14, 37–58. [Google Scholar] [CrossRef]
- Abdullahi, N. Advances in food packaging technology-A review. J. Postharvest Technol. 2018, 6, 55–64. [Google Scholar]
- Muller, J.; González-Martínez, C.; Chiralt, A. Combination of Poly(lactic) Acid and Starch for Biodegradable Food Packaging. Materials 2017, 10, 952. [Google Scholar] [CrossRef]
- Nida, S.; Moses, J.A.; Anandharamakrishnan, C. 3D Extrusion Printability of Sugarcane Bagasse Blended with Banana Peel for Prospective Food Packaging Applications. Sugar Tech. 2022, 24, 764–778. [Google Scholar] [CrossRef]
- Azmin, S.N.H.M.; Hayat, N.A.B.M.; Nor, M.S.M. Development and characterization of food packaging bioplastic film from cocoa pod husk cellulose incorporated with sugarcane bagasse fibre. J. Bioresour. Bioprod. 2020, 5, 248–255. [Google Scholar] [CrossRef]
- Avella, M.; Vlieger, J.J.; Errico, M.E.; Fischer, S.; Vacca, P.; Volpe, M.G. Biodegradable starch/clay nanocomposite films for food packaging applications. Food Chem. 2005, 93, 467–474. [Google Scholar] [CrossRef]
- Tripathi, S.; Mehrotra, G.K.; Dutta, P.K. Preparation and physicochemical evaluation of chitosan/poly(vinyl alcohol)/pectin ternary film for food-packaging applications. Carbohydr. Polym. 2010, 79, 711–716. [Google Scholar] [CrossRef]
- Bierhalz, A.C.K.; Silva, M.A.; Kieckbusch, T.G. Natamycin release from alginate/pectin films for food packaging applications. J. Food Eng. 2012, 110, 18–25. [Google Scholar] [CrossRef]
- Priyadarshi, R.; Rhim, J. Chitosan-based biodegradable functional films for food packaging applications. Innov. Food Sci. Emerg. Technol. 2020, 62, 102346. [Google Scholar] [CrossRef]
- Tripathi, S.; Mehrotra, G.K.; Dutta, P.K. Physicochemical and bioactivity of cross-linked chitosan–PVA film for food packaging applications. Int. J. Biol. Macromol. 2009, 45, 372–376. [Google Scholar] [CrossRef] [PubMed]
- Sarwar, M.S.; Niazi, M.B.K.; Jahan, Z.; Ahmad, T.; Hussain, A. Preparation and characterization of PVA/nanocellulose/Ag nanocomposite films for antimicrobial food packaging. Carbohydr. Polym. 2018, 184, 453–464. [Google Scholar] [CrossRef]
- Lu, P.; Yang, Y.; Liu, R.; Liu, X.; Ma, J.; Wu, M.; Wang, S. Preparation of sugarcane bagasse nanocellulose hydrogel as a colourimetric freshness indicator for intelligent food packaging. Carbohydr. Polym. 2020, 249, 116831. [Google Scholar] [CrossRef]
- Râpă, M.; Mitelut, A.C.; Tanase, E.E.; Grosu, E.; Popescu, P.; Popa, M.E.; Rosnes, J.T.; Sivertsvik, M.; Darie-Nita, R.N.; Vasile, C. Influence of chitosan on mechanical, thermal, barrier and antimicrobial properties of PLA-biocomposites for food packaging. Compos. B Eng. 2016, 102, 112–121. [Google Scholar] [CrossRef]
- Tokiwa, Y.; Calabia, B.P. Biodegradability and biodegradation of poly(lactide). Appl. Microbiol. Biotechnol. 2006, 72, 244–251. [Google Scholar] [CrossRef]
- Jiménez, L.; Mena, M.J.; Prendiz, J.; Salas, L.; Vega-Baudrit, J. Polylactic Acid (PLA) As A Bioplastic And Its Possible Applications In The Food Industry. Food Sci. Nutr. 2019, 5, 1–6. [Google Scholar]
- Luo, Y.; Lin, Z.; Guo, G. Biodegradation Assessment of Poly (Lactic Acid) Filled with Functionalized Titania Nanoparticles (PLA/TiO2) under Compost Conditions. Nanoscale Res. Lett. 2019, 14, 56. [Google Scholar] [CrossRef]
- Tabriz, K.R.; Katbab, A.A. Preparation of modified-TiO2/PLA nanocomposite films: Micromorphology, photo-degradability and antibacterial studies. AIP Conf. Proc. 2017, 1914, 070009. [Google Scholar]
- Pantani, R.; Gorrasi, G.; Vigliotta, G.; Murariu, M.; Dubois, P. PLA-ZnO nanocomposite films: Water vapor barrier properties and specific end-use characteristics. Eur. Polym. J. 2013, 49, 3471–3482. [Google Scholar] [CrossRef]
- Shankar, S.; Rhim, J.; Won, K. Preparation of poly(lactide)/lignin/silver nanoparticles composite films with UV light barrier and antibacterial properties. Int. J. Biol. Macromol. 2018, 107, 1724–1731. [Google Scholar] [CrossRef]
- Turalija, M.; Bischof, S.; Budimir, A.; Gaan, S. Antimicrobial PLA films from environment friendly additives. Compos. B Eng. 2016, 102, 94–99. [Google Scholar] [CrossRef]
- Qi, Y.; Ma, H.; Du, Z.; Yang, B.; Wu, J.; Wang, R.; Zhang, X. Hydrophilic and Antibacterial Modification of Poly(lactic acid) Films by γ-ray Irradiation. ACS Omega 2019, 4, 21439–21445. [Google Scholar] [CrossRef]
- Huang, Y.; Wang, T.; Zhao, X.; Wang, X.; Zhou, L.; Yang, Y.; Liao, F.; Ju, Y. Poly(lactic acid)/graphene oxide-ZnO nanocomposite films with good mechanical, dynamic mechanical, anti-UV and antibacterial properties. J. Chem. Technol. Biotechnol. 2015, 90, 1677–1684. [Google Scholar] [CrossRef]
- Shankar, S.; Wang, L.; Rhim, J. Incorporation of zinc oxide nanoparticles improved the mechanical, water vapor barrier, UV-light barrier, and antibacterial properties of PLA-based nanocomposite films. Mater. Sci. Eng. C 2018, 93, 289–298. [Google Scholar] [CrossRef]
- Pušnik Črešnar, K.; Aulova, A.; Bikiaris, D.N.; Lambropoulou, D.; Kuzmič, K.; Zemljič, L.F. Incorporation of Metal-Based Nanoadditives into the PLA Matrix: Effect of Surface Properties on Antibacterial Activity and Mechanical Performance of PLA Nanoadditive Films. Molecules 2021, 26, 4161. [Google Scholar] [CrossRef]
- Ramji, V.; Vishnuvarthanan, M. Influence of NiO Supported Silica Nanoparticles on Mechanical, Barrier, Optical and Antibacterial Properties of Polylactic Acid (PLA) Bio Nanocomposite Films for Food Packaging Applications. Silicon 2020, 14, 531–538. [Google Scholar] [CrossRef]
- Papadopoulou, E.L.; Paul, U.C.; Tran, T.N.; Suarato, G.; Ceseracciu, L.; Marras, S.; d’Arcy, R.; Athanassiou, A. Sustainable Active Food Packaging from Poly(lactic acid) and Cocoa Bean Shells. ACS Appl. Mater. Interfaces 2019, 11, 31317–31327. [Google Scholar] [CrossRef] [PubMed]
- Videira-Quintela, D.; Guillén, F.; Montalvo, G.; Martin, O. Silver, copper, and copper hydroxy salt decorated fumed silica hybrid composites as antibacterial agents. Colloids Surf. B Biointerfaces 2020, 195, 111216. [Google Scholar] [CrossRef] [PubMed]
- Videira-Quintela, D.; Guillén, F.; Martin, O.; Montalvo, G. Antibacterial LDPE films for food packaging application filled with metal-fumed silica dual-side fillers. Food Packag. Shelf. Life 2022, 31, 100772. [Google Scholar] [CrossRef]
- Chen, R.; Cheng, Y.; Wang, P.; Wang, Y.; Wang, Q.; Yang, Z.; Tang, C.; Xiang, S.; Luo, S.; Huang, S.; et al. Facile synthesis of a sandwiched Ti3C2Tx MXene/nZVI/fungal hypha nanofiber hybrid membrane for enhanced removal of Be(II) from Be(NH) complexing solutions. Chem. Eng. J. 2021, 421, 129682. [Google Scholar] [CrossRef]
- Li, Z.; Wang, L.; Sun, D.; Zhang, Y.; Liu, B.; Hu, Q.; Zhou, A. Synthesis and thermal stability of two-dimensional carbide MXene Ti3C2. Mater. Sci. Eng. B 2015, 191, 33–40. [Google Scholar] [CrossRef]
- Shuck, C.E.; Sarycheva, A.; Anayee, M.; Levitt, A.; Zhu, Y.; Uzun, S.; Balitskiy, V.; Zahorodna, V.; Gogotsi, O.; Gogotsi, Y. Scalable Synthesis of Ti3C2Tx MXene. Adv. Eng. Mater. 2020, 22, 1901241. [Google Scholar] [CrossRef]
- Gong, X.; Pan, L.; Tang, C.Y.; Chen, L.; Hao, Z.; Law, W.; Wang, X.; Tsui, C.P.; Wu, C. Preparation, optical and thermal properties of CdSe–ZnS/poly(lactic acid) (PLA) nanocomposites. Compos. B 2014, 66, 494–499. [Google Scholar] [CrossRef]
- Jonoobi, M.; Harun, J.; Mathew, A.P.; Oksman, K. Mechanical properties of cellulose nanofiber (CNF) reinforced polylactic acid (PLA) prepared by twin screw extrusion. Compos. Sci. Technol 2010, 70, 1742–1747. [Google Scholar] [CrossRef]
- Petersson, L.; Oksman, K. Biopolymer based nanocomposites: Comparing layered silicates and microcrystalline cellulose as nanoreinforcement. Compos. Sci. Technol. 2006, 66, 2187–2196. [Google Scholar] [CrossRef]
- Jastrzębska, A.M.; Szuplewska, A.; Wojciechowski, T.; Chudy, M.; Ziemkowska, W.; Chlubny, L.; Rozmyslowska, A.; Olszyna, A. In vitro studies on cytotoxicity of delaminated Ti3C2 MXene. J. Hazard. Mater. 2017, 339, 1–8. [Google Scholar] [CrossRef]
- Rasool, K.; Mahmoud, K.A.; Johnson, D.J.; Helal, M.; Berdiyorov, G.R.; Gogotsi, Y. Efficient Antibacterial Membrane based on Two-Dimensional Ti3C2Tx (MXene) Nanosheets. Sci. Rep. 2017, 7, 1598. [Google Scholar] [CrossRef]

| Sample | Tg, °C | Tcon set, °C | Tmon set, °C | ΔHc, J/g | ΔHm, J/g |
|---|---|---|---|---|---|
| PLA | 58 | 105 | 142 | 290 | 59 |
| PLA + 0.3% MXene | 58 | 104 | 142 | 301 | 67 |
| PLA + 1% MXene | 58 | 105 | 143 | 328 | 80 |
| PLA + 5% MXene | 58 | 105 | 143 | 350 | 81 |
| Material | Tonset, °C | Tpeak, °C |
|---|---|---|
| PLA | 336 | 377 |
| PLA + 0.3% MXene | 327 | 366 |
| PLA + 1% MXene | 320 | 360 |
| PLA + 5% MXene | 320 | 358 |
| Sample | Thickness, mm | Width, mm | Length, mm | σmax, MPa | εmax, % | E, GPa |
|---|---|---|---|---|---|---|
| PLA | 0.05 ± 0.01 | 2.0 ± 0.1 | 8.78 ± 0.09 | 40 ± 10 | 14 ± 7 | 2.6 ± 0.4 |
| PLA + 0.3% MXene | 0.05 ± 0.01 | 2.13 ± 0.07 | 8.8 ± 0.1 | 41 ± 6 | 12 ± 3 | 2.9 ± 0.5 |
| PLA + 1% MXene | 0.05 ± 0.01 | 2.1 ± 0.09 | 8.80 ± 0.08 | 42 ± 8 | 10 ± 5 | 2.9 ± 0.5 |
| PLA + 5% MXene | 0.03 ± 0.01 | 2.04 ± 0.05 | 8.74 ± 0.01 | 68 ± 10 | 4.7 ± 0.2 | 4.8 ± 0.6 |
| Filler | Polymer | Bacteria | Log Reduction | Ref. |
|---|---|---|---|---|
| TiO2 | PLA | Escherichia coli Staphylococcus aureus | ~0.7 ~0.2 | [32] |
| ZnO | PLA | Escherichia coli Staphylococcus aureus | ~3.4 ~2.9 | [33] |
| AgNPs | PLA | Escherichia coli Listeria monocytogenes | ~10 ~9.8 | [34] |
| Ag | PLA | Staphylococcus aureus Escherichia coli Listeria monocytogenes Salmonella Typhimurium | ~2.7 ~7.2 ~6.1 ~7.4 | [35] |
| AgNPs | PLA | Escherichia coli Staphylococcus aureus | ~6.3 ~4.6 | [36] |
| GO/ZnO | PLA | Staphylococcus aureus Escherichia coli | ~2.1 ~1.6 | [37] |
| ZnO NPs | PLA | Escherichia coli Listeria monocytogenes | ~6.6 ~4.3 | [38] |
| Ag, ZnO, TiO2 | PLA | Staphylococcus aureus Escherichia coli | ~0.4 ~8.0 (PLA-AgNPs) | [39] |
| NiO NPs supported on SiO2 | PLA | Listeria monocytogenes Salmonella | ~0.9 ~1.0 | [40] |
| MXene | Nanocellulose | Escherichia coli Staphylococcus aureus | ~1.6 ~1.8 | [14] |
| MXene | PVDF | Escherichia coli Bacillus subtilis | ~2.3 ~2.3 | [51] |
| MXene | PLA | Listeria monocytogenes Salmonella | ~6.0 ~5.2 | This work |
Publisher’s Note: MDPI stays neutral with regard to jurisdictional claims in published maps and institutional affiliations. |
© 2022 by the authors. Licensee MDPI, Basel, Switzerland. This article is an open access article distributed under the terms and conditions of the Creative Commons Attribution (CC BY) license (https://creativecommons.org/licenses/by/4.0/).
Share and Cite
Santos, X.; Álvarez, M.; Videira-Quintela, D.; Mediero, A.; Rodríguez, J.; Guillén, F.; Pozuelo, J.; Martín, O. Antibacterial Capability of MXene (Ti3C2Tx) to Produce PLA Active Contact Surfaces for Food Packaging Applications. Membranes 2022, 12, 1146. https://doi.org/10.3390/membranes12111146
Santos X, Álvarez M, Videira-Quintela D, Mediero A, Rodríguez J, Guillén F, Pozuelo J, Martín O. Antibacterial Capability of MXene (Ti3C2Tx) to Produce PLA Active Contact Surfaces for Food Packaging Applications. Membranes. 2022; 12(11):1146. https://doi.org/10.3390/membranes12111146
Chicago/Turabian StyleSantos, Xiomara, Marcos Álvarez, Diogo Videira-Quintela, Aranzazu Mediero, Juana Rodríguez, Francisco Guillén, Javier Pozuelo, and Olga Martín. 2022. "Antibacterial Capability of MXene (Ti3C2Tx) to Produce PLA Active Contact Surfaces for Food Packaging Applications" Membranes 12, no. 11: 1146. https://doi.org/10.3390/membranes12111146
APA StyleSantos, X., Álvarez, M., Videira-Quintela, D., Mediero, A., Rodríguez, J., Guillén, F., Pozuelo, J., & Martín, O. (2022). Antibacterial Capability of MXene (Ti3C2Tx) to Produce PLA Active Contact Surfaces for Food Packaging Applications. Membranes, 12(11), 1146. https://doi.org/10.3390/membranes12111146

